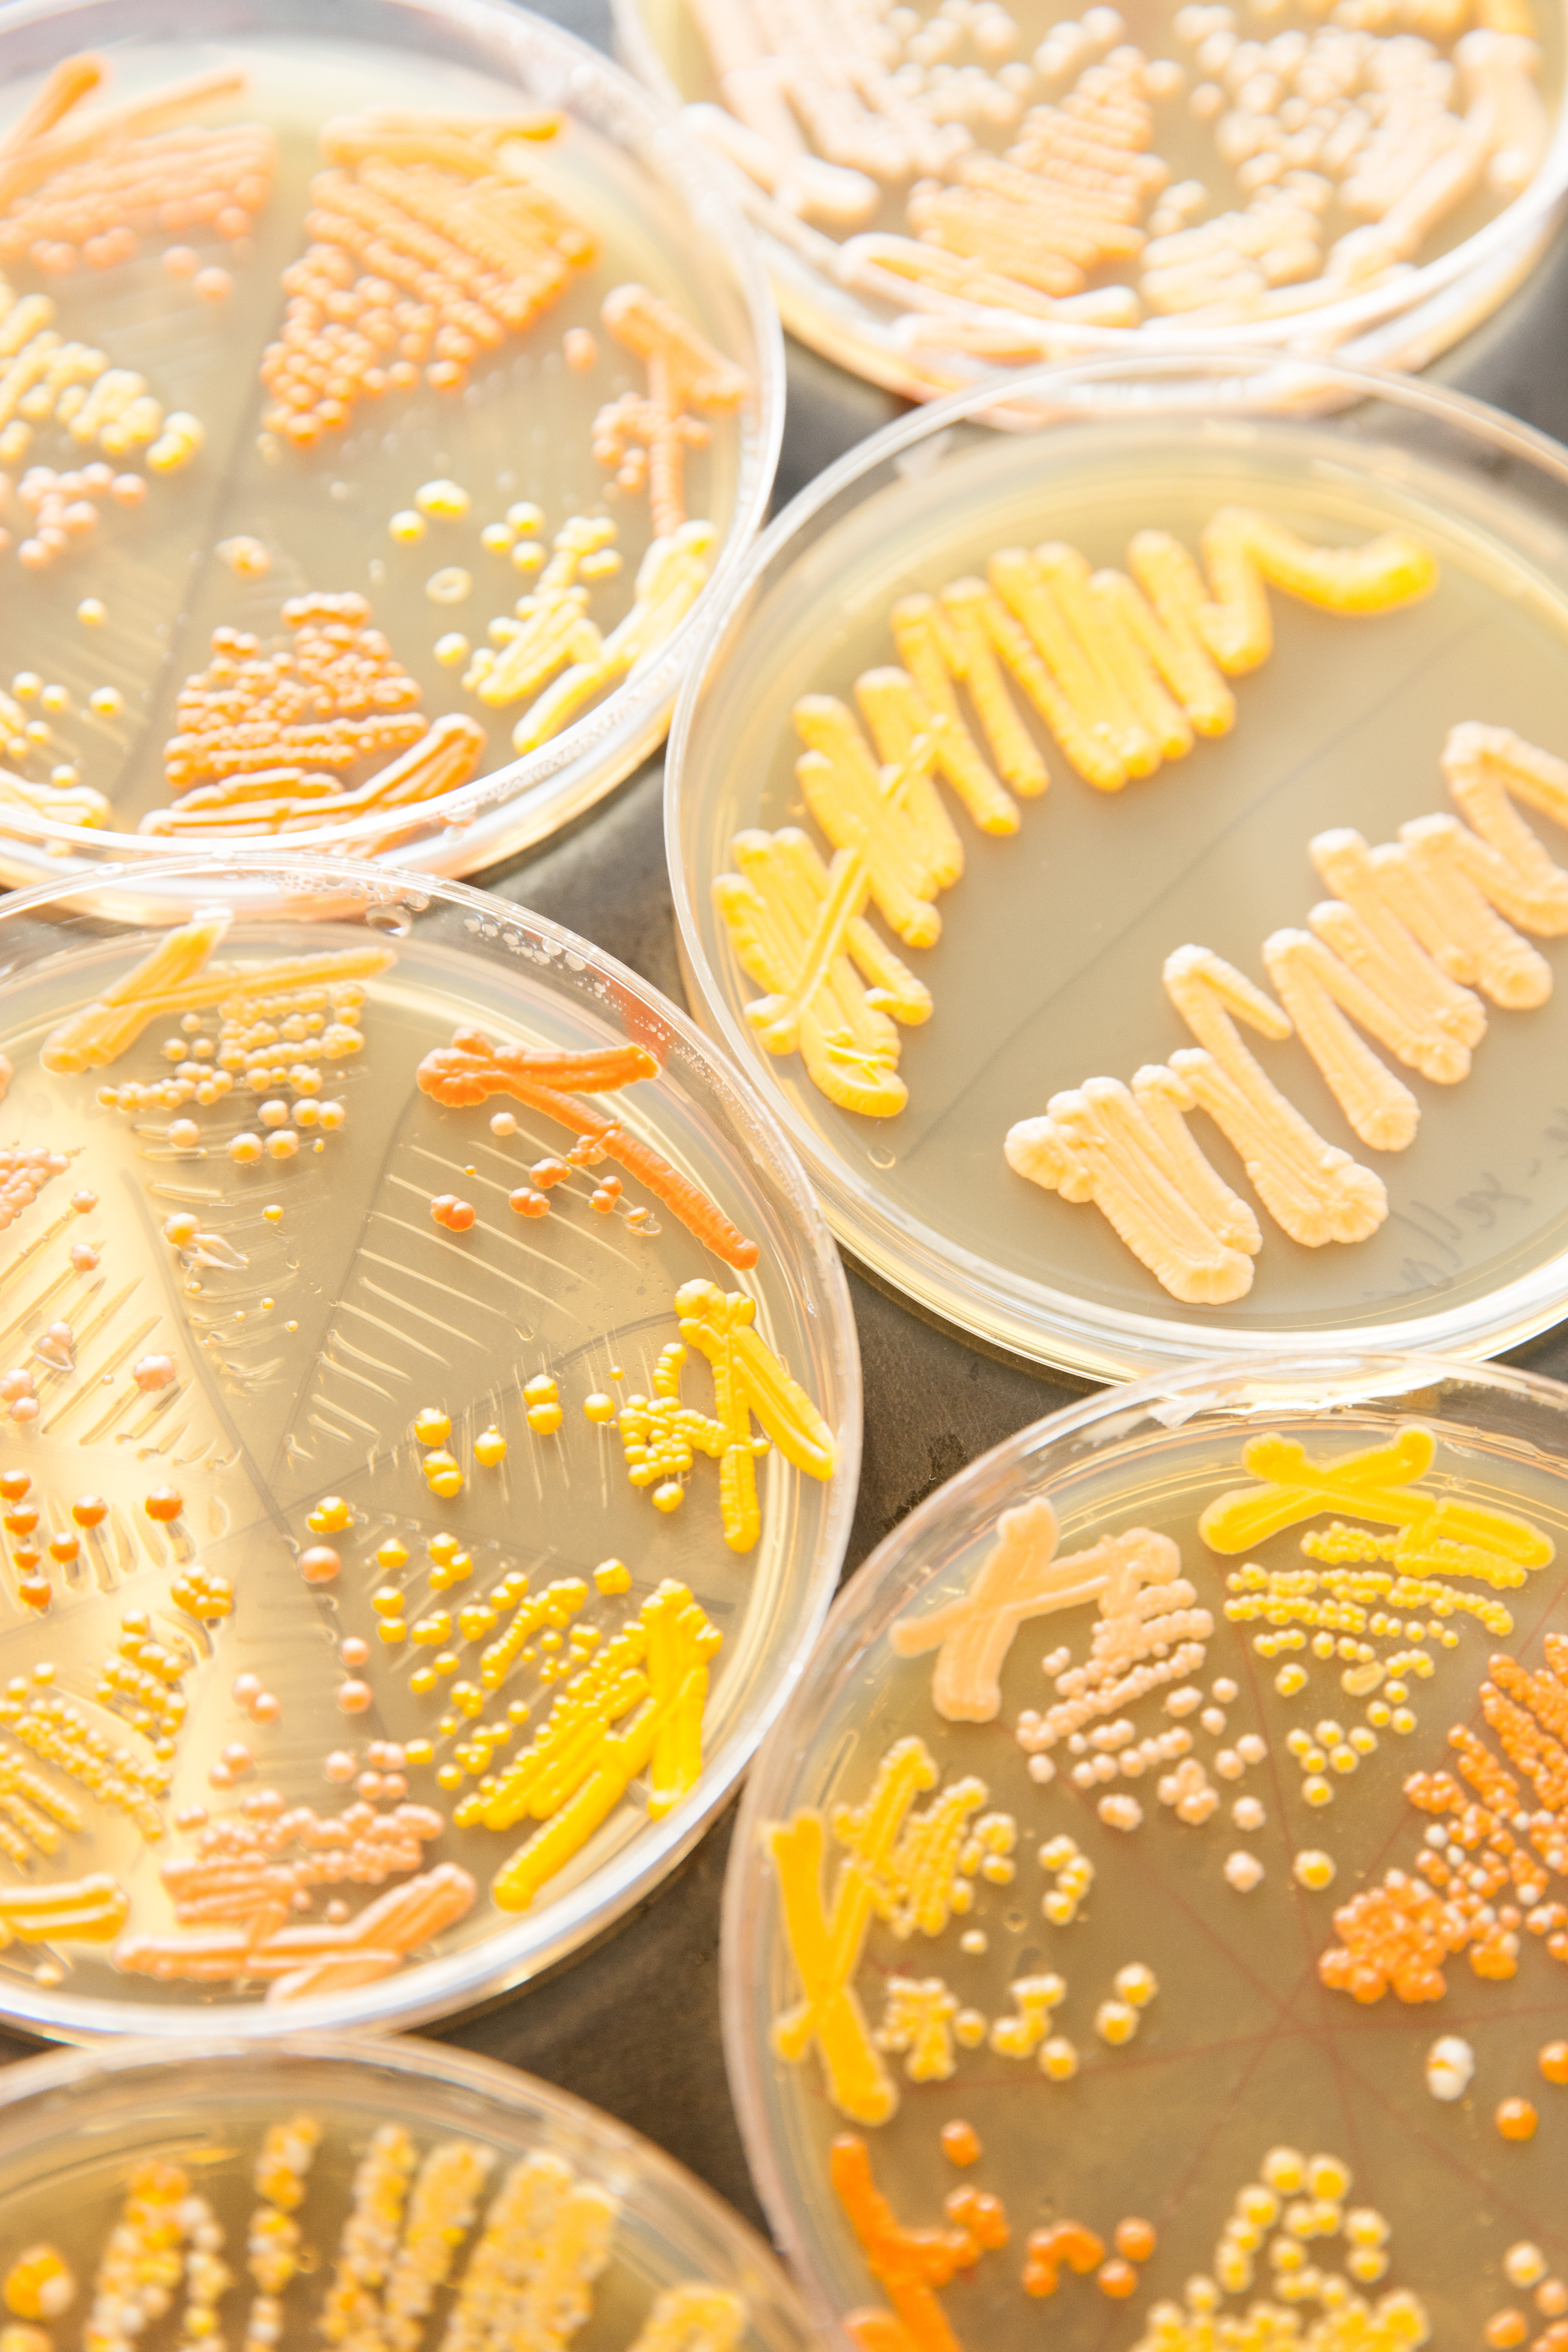

La investigación está recreando artificialmente los 16 cromosomas del hongo unicelular responsable de la cerveza. Su éxito podría conducir a algas de diseño que producen combustible, órganos a prueba de enfermedades e incluso la resurrección de especies extintas